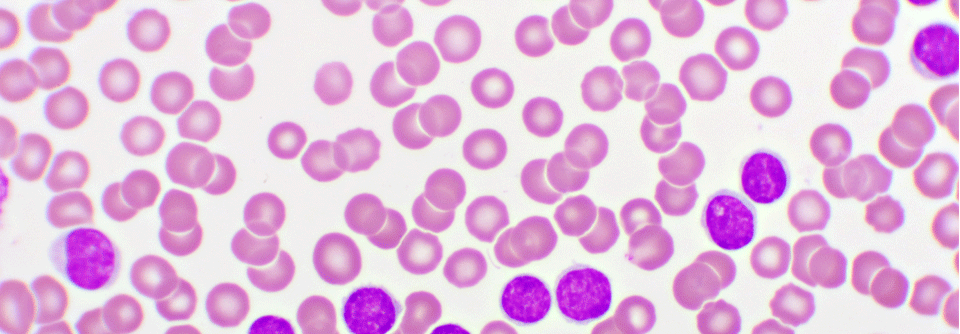

CML Asciminib auf Partnersuche
 Asciminib wurde in der Studie mit verschiedenen kovalenten TKI kombiniert.
© Anisah – stock.adobe.com
Asciminib wurde in der Studie mit verschiedenen kovalenten TKI kombiniert.
© Anisah – stock.adobe.com
Zwar wurde im ersten Jahr der Studie FASCINATION bei CML-Patient:innen mit der Kombination aus Asciminib und TKI eine hohe Rate eines tiefen molekularen Ansprechens erreicht; allerdings tolerierten die Teilnehmenden die Kombinationen nur mäßig gut, berichtete Prof. Dr. Thomas Ernst vom Universitätsklinikum Jena. In den Folgejahren besserte sich das Nutzen-Risiko-Profil. Der Referent stellte jetzt die Drei-Jahres-Daten der prospektiven Multicenterstudie vor.
Liebe Leserin, lieber Leser, aus rechtlichen Gründen ist der Beitrag, den Sie aufrufen möchten, nur für medizinische Fachkreise zugänglich. Wenn Sie diesen Fachkreisen angehören (Ärzte, Apotheker, Medizinstudenten, medizinisches Fachpersonal, Mitarbeiter der pharmazeutischen oder medizintechnischen Industrie, Fachjournalisten), loggen Sie sich bitte ein oder registrieren sich auf unserer Seite. Der Zugang ist kostenlos.
Benutzeranmeldung
Bitte geben Sie Ihren Benutzernamen und Ihr Passwort ein, um sich an der Website anzumelden.
Bei Fragen zur Anmeldung senden Sie bitte eine Mail an online@medical-tribune.de.



